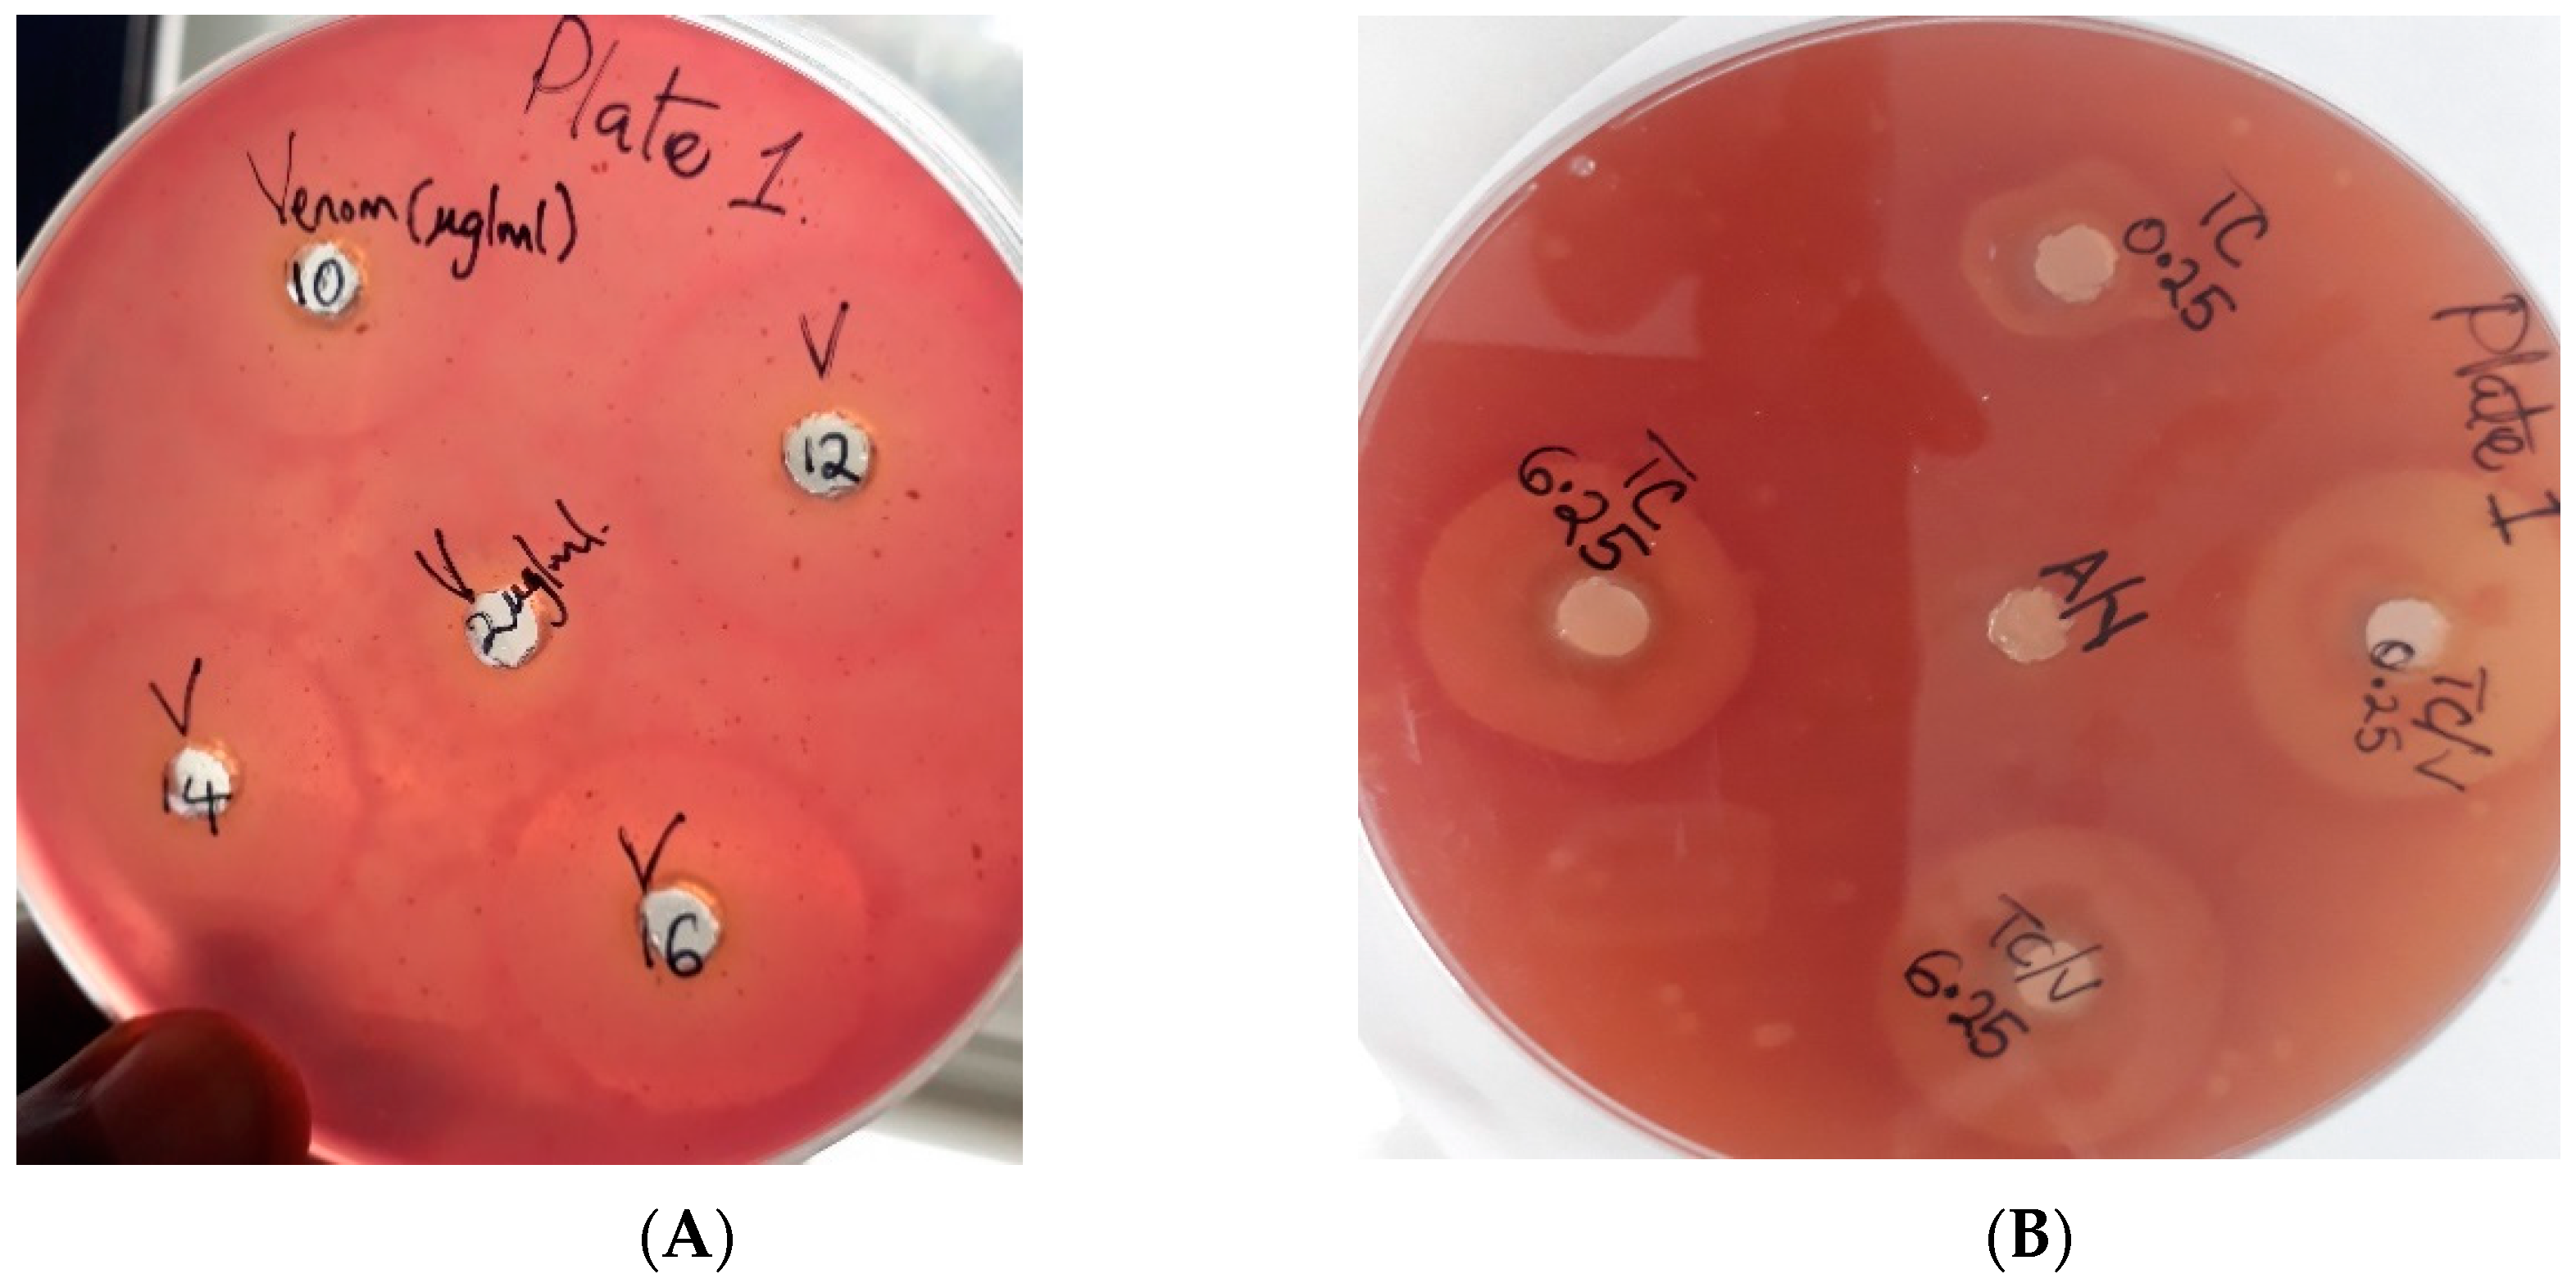
Molecules 28 03089 g002 Molecules 28 03089 g002

In Vitro Anti-Venom Potentials of Aqueous Extract and Oils of Toona ciliata M. Roem against Cobra Venom and Chemical Constituents of Oils
Abstract
1. Introduction
2. Results
2.1. Phytochemical Screening
2.2. Lethal Dose (LD50) of Venom
Probit Analysis to Determine LD50
2.3. Administration of a Mixture of Venom and Plant Extracts after the Pre-Incubation Test
2.4. In vitro Inhibition of Anticoagulant Activities of Venom
2.4.1. Minimum Coagulation Dose of Plasma (MCD-P)
2.4.2. Inhibition of the Anticoagulation Activity of Venom
2.5. Inhibition of Phospholipase A2 (PLA2) Activity of Venom
2.5.1. Determination of Minimum PLA2 Hemolytic Dose of Venom
2.5.2. Inhibition of PLA2 Hemolytic Activities of Venom by Extract
2.6. Anti-Venom Activities of Non-Volatile and Volatile Oils of T Ciliata by SDS-PAGE
2.7. Chemical Composition of Non-Volatile and Volatile Oils by GC-MS/MS
2.7.1. Phytocompounds in Isolated Non-Volatile Oils
2.7.2. Phytocompounds in the Volatile Oil
3. Discussion
3.1. Phytochemical Screening
3.2. In Vitro Anti-Venom Potentials of Aqueous Extract of T. ciliata
3.3. Inhibition of Anticoagulant Activities of Venom
3.4. Inhibition of Phospholipase A2 Activities
3.5. In Vitro Anti-Venom Potentials of Oils of T. ciliata by SDS-PADE
3.6. Chemical Constituents of Non-Volatile and Volatile Oils of T. ciliata Root Bark by GC-MS/MS
4. Materials and Methods
4.1. Ethical Approval
4.2. Milking and Lyophilizing of Venom
4.3. Source of Plants Material
4.4. Extraction of the Plant Material
4.5. Phytochemicals Screening
4.6. Anti-Venom Potentials of Toona ciliata
4.6.1. Experimental Animals
4.6.2. Lethal Dose (LD50) Determination of Venom
4.6.3. Neutralization of Venom by Aqueous Extract
Administration of the Mixture of Venom and Aqueous Plant Extract
4.7. Inhibition of Anticoagulant Activities of Venom
4.7.1. Determination of Minimum Coagulation Dose of Plasma (MCD-P) by Venom
4.7.2. Determination of Effects of T. ciliata Extract on Coagulation of Plasma
4.7.3. Neutralization of Anticoagulation Activity of Venom
4.8. Inhibition of Phospholipase A2 Activity of Venom
4.8.1. Determination of Minimum Hemolytic Dose of Venom and T. ciliata Extract
4.8.2. Neutralization of Minimum Hemolytic Dose of Venom
4.9. Fractionation of the Organic Extract of T. ciliata
4.9.1. Hydro-Distillation of Volatile Oils from Root Barks of T. ciliata
4.9.2. Anti-Venom Activities of Non-Volatile and Volatile Oils of T. ciliata by SDS-PAGE
SDS-PAGE Gel Electrophoresis
4.9.3. GC-MS/MS Analysis of Non-Volatile (NVO1, NVO2 and NVO3) and Volatile Oils
4.9.4. Identification of Chemical Compounds of Both Non-Volatile and Volatile Oils
5. Conclusions
Author Contributions
Funding
Institutional Review Board Statement
Informed Consent Statement
Data Availability Statement
Acknowledgments
Conflicts of Interest
References
- WHO. WHO Guidelines for the Production, Control and Regulation of Snake Antivenom Immunoglobulins; WHO: Geneva, Switzerland, 2010. [Google Scholar]
- Chippaux, J.P. Snakebite envenomation turns again into a neglected tropical disease. J. Venom. Anim. Toxins Incl. Trop. Dis. 2017, 23, 38. [Google Scholar] [CrossRef]
- Warrell, D.A. Snake bite. Lancet 2010, 375, 77–88. [Google Scholar] [CrossRef]
- Gutiérrez, J.M.; Warrell, D.A.; Williams, D.J.; Jensen, S.; Brown, N.; Calvete, J.J.; Harrison, R.A.; Initiative, G.S. The need for full integration of snakebite envenoming within a global strategy to combat the neglected tropical diseases: The way forward. PLoS Negl. Trop. Dis. 2013, 7, e21622013. [Google Scholar] [CrossRef] [PubMed]
- Brown, N.I. Consequences of neglect: Analysis of the sub-Saharan African snake antivenom market and the global context. PLoS Negl. Trop. Dis. 2012, 6, e16702012. [Google Scholar] [CrossRef] [PubMed]
- Swaroop, S.; Grab, B. Snakebite mortality in the world. Bull. World Health Organ. 1954, 10, 35. [Google Scholar] [PubMed]
- Cruz, L.S.; Vargas, R.; Lopes, A.A. Snakebite envenomation and death in the developing world. Ethn. Dis. 2009, 19, 42. [Google Scholar]
- Mavoungou, L.B.; Jackson, K.; Goma-Tchimbakala, J. Prevalence and therapeutic management of snakebite cases in the health facilities of the Bouenza department from 2009 to 2021, Republic of Congo. Pan Afr. Med. J. 2022, 42, 139. [Google Scholar]
- Schurer, J.M.; Dam, A.; Mutuyimana, M.T.; Runanira, D.M.; Nduwayezu, R.; Amuguni, J.H. “At the hospital they do not treat venom from snakebites”: A qualitative assessment of health seeking perspectives and experiences among snakebite victims in Rwanda. Toxicon X 2022, 14, 100100. [Google Scholar] [CrossRef] [PubMed]
- Nduwayezu, R.; Kinney, H.; Amuguni, J.H.; Schurer, J.M. Snakebite Envenomation in Rwanda: Patient Demographics, Medical Care, and Antivenom Availability in the Formal Healthcare Sector. Am. J. Trop. Med. Hyg. 2021, 104, 316–322. [Google Scholar] [CrossRef]
- Bwambale, T. Snake Bites Cause 30,000 Death in Africa; New Vision: Kampala, Uganda, 2017. [Google Scholar]
- Nabatanzi, V. Kamuli, Mubende, Gulu Top in Number of Snakebites; New Vision: Kampala, Uganda, 2018. [Google Scholar]
- Warrell, D.A. WHO, Guidelines for the Prevention and Clinical Management of Snakebite in Afrika; WHO: Geneva, Switzerland, 2010. [Google Scholar]
- Gold, B.S.; Wingert, W.A. Snake venom poisoning in the United States: A review of therapeutic practice. South. Med. J. 1994, 87, 579–589. [Google Scholar] [CrossRef]
- Theakston, R.; Reid, H. Development of simple standard assay procedures for the characterization of snake venoms. Bull. World Health Organ. 1983, 61, 949. [Google Scholar] [PubMed]
- Teixeira, C.d.F.P.; Landucci, E.; Antunes, E.; Chacur, M.; Cury, Y. Inflammatory effects of snake venom myotoxic phospholipases A2. Toxicon 2003, 42, 947–962. [Google Scholar] [CrossRef] [PubMed]
- Shah, K.B.; Sherstha, J.M.; Thapa, C.L. Snakebite Management Guideline; Epidemiology and Disease Control Division, Department of Health Services, Zoonoses Control Sub-Section, Government of Nepal: Kathmandu, Nepal, 2003. [Google Scholar]
- Asad, M.H.H.B.; Razi, M.T.; Durr-e-Sabih; Najamus-Saqib, Q.; Nasim, S.J.; Murtaza, G.; Hussain, I. Anti-venom potential of Pakistani medicinal plants: Inhibition of anticoagulation activity of Naja naja karachiensis toxin. Curr. Sci. 2013, 105, 1419–1424. [Google Scholar]
- Deshpande, A.M.; Sastry, K.V.; Bhise, S.B. A contemporary exploration of traditional Indian snake envenomation therapies. Trop. Med. Infect. Dis. 2022, 7, 108. [Google Scholar] [CrossRef]
- Naseeb, K.; Karunakar, H.; Aamir, S.; Deepak, T.; Ashar, K. Evaluation of antivenom activity of ethanolic extract of Buchanania lanzan bark against Naja kaouthia snake venom. Unique J. Pharm. Biol. Sci. 2014, 2, 39–45. [Google Scholar]
- Meenatchisundaram, S.; Michael, A. Antitoxin activity of Mucuna pruriens aqueous extracts against cobra and krait venom by In Vivo and In Vitro methods. Int. J. PharmTech Res. 2010, 2, 870–874. [Google Scholar]
- Ndlovu, M.J. Screening of the Crude Acetone Extracts of Toona ciliata, seriphium plumosum and schkuhria pinnata for Their Potential Anticancer Activities Against Hela Cervical Cancer Cells. Ph.D. Thesis, University of Limpopo, Mankweng, South Africa, 2019. [Google Scholar]
- Wang, X.; Xiao, Y.; He, Z.-H.; Li, L.-L.; Lv, Y.-W.; Hu, X.-S. Evolutionary divergence between Toona ciliata and Toona sinensis assayed with their whole genome sequences. Genes 2022, 13, 1799. [Google Scholar] [CrossRef]
- Kavitha, K.S.; Satish, S. Evaluation of antimicrobial and antioxidant activities from Toona ciliata Roemer. J. Anal. Sci. Tech. 2013, 4, 1–7. [Google Scholar] [CrossRef]
- Hanif, S.; Alsaiari, M.; Ahmad, M.; Sultana, S.; Zafar, M.; Rozina; Harraz, F.A.; Alharbi, A.F.; Abahussain, A.A.M.; Ahmad, Z. Membrane reactor based synthesis of biodiesel from Toona ciliata seed oil using barium oxide nano catalyst. Chemosphere 2022, 308, 136458. [Google Scholar] [CrossRef]
- Duan, D.; Chen, L.; Yang, X.; Tu, Y.; Jiao, S. Antidepressant-like effect of essential oil isolated from Toona ciliata Roem. var. yunnanensis. J. Nat. Med. 2015, 69, 191–197. [Google Scholar] [CrossRef]
- Maia, B.H.; Paula, J.R.d.; Sant’Ana, J.; Silva, M.; Fernandes, J.B.; Vieira, P.C.; Costa, M.D.S.; Ohashi, O.S.; Silva, J.N.M. Essential oils of Toona and Cedrela species (Meliaceae): Taxonomic and ecological implications. J. Braz. Chem. Soc. 2000, 11, 629–639. [Google Scholar] [CrossRef]
- Okot, D.F.; Anywar, G.; Namukobe, J.; Byamukama, R. Medicinal plants species used by herbalists in the treatment of snakebite envenomation in Uganda. Trop. Med. Health 2020, 48, 1–14. [Google Scholar] [CrossRef] [PubMed]
- Ntume, R.; Anywar, G. Ethnopharmacological survey of medicinal plants used in the treatment of snakebites in Central Uganda. Curr. Life Sci. 2015, 1, 6–14. [Google Scholar]
- Kankara, I.A.; Abdullahi, I.; Paulina, G.A. Ethnomedicinal plants: A source of phytochemical compounds against snake venom PLA2s activity. J. Pharm. Phytochem. 2020, 9, 1270–1275. [Google Scholar]
- Gopi, K.; Anbarasu, K.; Renu, K.; Jayanthi, S.; Vishwanath, B.; Jayaraman, G. Quercetin-3-O-rhamnoside from Euphorbia hirta protects against snake Venom induced toxicity. Biochim. Biophy. Acta Gen. Subj. 2016, 1860, 1528–1540. [Google Scholar] [CrossRef]
- Singh, P.; Yasir, M.; Hazarika, R.; Sugunan, S.; Shrivastava, R. A review on venom enzymes neutralizing ability of secondary metabolites from medicinal plants. J. Pharmacopunct. 2017, 20, 173. [Google Scholar]
- Fry, B. Venomous Reptiles and Their Toxins: Evolution, Pathophysiology and Biodiscovery; Oxford University Press: Oxdord, UK, 2015. [Google Scholar]
- Deshpande, A.M.; Sastry, K.V.; Bhise, S.B. Neutralization of Naja naja and Daboia russelii snake venoms by aqueous plant extracts. J. Appl. Pharm. Sci. 2022, 12, 086–095. [Google Scholar] [CrossRef]
- Adzu, B.; Abubakar, M.; Izebe, K.; Akumka, D.; Gamaniel, K. Effect of Annona senegalensis root bark extracts on Naja nigricotlis nigricotlis venom in rats. J. Ethnopharmacol. 2005, 96, 507–513. [Google Scholar] [CrossRef]
- Abubakar, M.; Sule, M.; Pateh, U.; Abdurahman, E.; Haruna, A.; Jahun, B. In vitro snake venom detoxifying action of the leaf extract of Guiera senegalensis. J. Ethnopharmacol. 2000, 69, 253–257. [Google Scholar] [CrossRef]
- Kazandjian, T.D.; Arrahman, A.; Still, K.B.; Somsen, G.W.; Vonk, F.J.; Casewell, N.R.; Wilkinson, M.C.; Kool, J. Anticoagulant activity of Naja nigricollis venom is mediated by phospholipase A2 toxins and inhibited by varespladib. Toxins 2021, 13, 302. [Google Scholar] [CrossRef]
- Bittenbinder, M.A.; Zdenek, C.N.; Op den Brouw, B.; Youngman, N.J.; Dobson, J.S.; Naude, A.; Vonk, F.J.; Fry, B.G. Coagulotoxic cobras: Clinical implications of strong anticoagulant actions of African spitting Naja Venoms that are not neutralised by antivenom but are by LY315920 (Varespladib). Toxins 2018, 10, 516. [Google Scholar] [CrossRef] [PubMed]
- Krishnaswamy, S. The transition of prothrombin to thrombin. J. Thromb. Haemost. 2013, 11, 265–276. [Google Scholar] [CrossRef] [PubMed]
- Fry, B.G.; Roelants, K.; Champagne, D.E.; Scheib, H.; Tyndall, J.D.; King, G.F.; Nevalainen, T.J.; Norman, J.A.; Lewis, R.J.; Norton, R.S. The toxicogenomic multiverse: Convergent recruitment of proteins into animal venoms. Annu. Rev. Genom. Hum. Gen. 2009, 10, 483–511. [Google Scholar] [CrossRef]
- Osipov, A.V.; Filkin, S.Y.; Makarova, Y.V.; Tsetlin, V.I.; Utkin, Y.N. A new type of thrombin inhibitor, noncytotoxic phospholipase A2, from the Naja haje cobra venom. Toxicon 2010, 55, 186–194. [Google Scholar] [CrossRef] [PubMed]
- Babaie, M.; Zolfagharian, H.; Salmanizadeh, H.; Mirakabadi, A.Z.; Alizadeh, H. Isolation and partial purification of anticoagulant fractions from the venom of the Iranian snake Echis carinatus. Acta Biochim. Polon. 2013, 60, 17–20. [Google Scholar] [CrossRef] [PubMed]
- Zingali, R.B. Interaction of snake-venom proteins with blood coagulation factors: Mechanisms of anticoagulant activity. Toxin Rev. 2007, 26, 25–46. [Google Scholar] [CrossRef]
- Zohra, M.; Fawzia, A. Hemolytic activity of different herbal extracts used in Algeria. Int. J. Pharma Sci. Res. 2014, 5, 495–500. [Google Scholar]
- Kaushik, A.; Tesfai, T.S.; Barkh, D.K.; Ghebremeskel, F.K.; Zerihun, H.G.; Woldeab, S.W. Evaluation of Snake Venom’s PhospholipaseA2 Enzyme Inhibition Activity of Cyphostemma adenocoule. Curr. Chem. Biol. 2020, 14, 196–202. [Google Scholar] [CrossRef]
- Costa, T.R.; Francisco, A.F.; Cardoso, F.F.; Moreira-Dill, L.S.; Fernandes, C.A.; Gomes, A.A.; Guimarães, C.L.; Marcussi, S.; Pereira, P.S.; Oliveira, H.C. Gallic acid anti-myotoxic activity and mechanism of action, a snake venom phospholipase A2 toxin inhibitor, isolated from the medicinal plant Anacardium humile. Int. J. Biol. Macromol. 2021, 185, 494–512. [Google Scholar] [CrossRef]
- Cáceres, M.I.; Ricciardi, G.A.; Torres, A.M.; Ricciardi, B.V.; Ferrero, S.; Dellacassa, E. In Vitro anti-snake venom activities of Aloysia citriodora Palau: New possibilities for a known aromatic plant. J. Essen. Oil Bear. Plants 2017, 20, 132–140. [Google Scholar] [CrossRef]
- Vera-Palacios, A.; Sacoto-Torres, J.; Hernández-Altamirano, J.; Moreno, A.; Peñuela-Mora, M.; Salazar-Valenzuela, D.; Mogollón, N.; Almeida, J. A First Look at the Inhibitory Potential of Urospatha sagittifolia (Araceae) Ethanolic Extract for Bothrops atrox Snakebite Envenomation. Toxins 2022, 14, 496. [Google Scholar] [CrossRef] [PubMed]
- Kozioł, E.; Luca, S.V.; Ağalar, H.G.; Sağlık, B.N.; Demirci, F.; Marcourt, L.; Wolfender, J.-L.; Jóźwiak, K.; Skalicka-Woźniak, K. Rutamarin: Efficient liquid–liquid chromatographic isolation from Ruta graveolens L. and evaluation of its In Vitro and in silico MAO-B inhibitory activity. Molecules 2020, 25, 2678. [Google Scholar] [CrossRef] [PubMed]
- Tipton, K. Enzymology of monoamine oxidase. Cell. Biochem. Modul. Act. Agents Dis. 1986, 4, 79–87. [Google Scholar] [CrossRef]
- Kennedy, B.; Ziegler, M.; Alford, M.; Hansen, L.; Thal, L.; Masliah, E. Early and persistent alterations in prefrontal cortex MAO A and B in Alzheimer’s disease. J. Neural Transm. 2003, 110, 789–801. [Google Scholar] [CrossRef] [PubMed]
- Edmondson, D.E.; Binda, C. Monoamine oxidases. Membr. Protein Complexes Struct. Funct. 2018, 87, 117–139. [Google Scholar]
- Kim, K.H.; Lee, D.; Lee, H.L.; Kim, C.E.; Jung, K.; Kang, K.S. Beneficial effects of Panax ginseng for the treatment and prevention of neurodegenerative diseases: Past findings and future directions. J. Ginseng Res. 2018, 42, 239–247. [Google Scholar] [CrossRef]
- Cho, I.H. Volatile compounds of ginseng (Panax sp.): A review. J. Korean Soc. Appl. Biol. Chem. 2015, 58, 67–75. [Google Scholar] [CrossRef]
- Guo, S.-S.; Wang, Y.; Chen, Z.-Y.; Zhang, Z.; Cao, J.-Q.; Pang, X.; Geng, Z.-F.; Du, S.-S. Essential Oils from Clausena Species in China: Santalene Sesquiterpenes Resource and Toxicity against Liposcelis bostrychophila. J. Chem. 2018, 2018, 7813675. [Google Scholar] [CrossRef]
- Türkez, H.; Celik, K.; Toğar, B. Effects of copaene, a tricyclic sesquiterpene, on human lymphocytes cells In Vitro. Cytotechnology 2014, 66, 597–603. [Google Scholar] [CrossRef]
- Miranda, C.A.S.F.D.; Cardoso, M.D.G.; Marcussi, S.; Teixeira, M.L. Clotting and fibrinogenolysis inhibition by essential oils from species of the Asteraceae family. Braz. Arch. Biol. Techn. 2016, 59, 1678–4324. [Google Scholar] [CrossRef]
- Jaouadi, I.; Abdelkafi-Koubaa, Z.; Riabi-Ayari, S.; Hassen, I.; Yakoubi, M.T.; Ayeb, M.E.; Gazzah, M.E.; Marrakchi, N. Anti-hemolytic and Anti-cytotoxic Effect of Two Artemisia Species (A. campestris and A. herba-alba) Essential Oil against Snake Venom. Int. J. Agric. Biol. 2016, 18, 805–812. [Google Scholar] [CrossRef]
- Cuéllar, M.J.; Giner, R.M.; Recio, M.C.; Just, M.J.; Máñez, S.; Cerda, M.; Hostettmann, K.; Ríos, J.-L. Zanhasaponins A and B, antiphospholipase A2 saponins from an antiinflammatory extract of Zanha africana root bark. J. Nat. Prod. 1997, 60, 1158–1160. [Google Scholar] [CrossRef] [PubMed]
- Elaiyaraja, A.; Chandramohan, G. Comparative phytochemical profile of Indoneesiella echioides (L) nees leaves. J. Pharmacogn. Phytochem. 2016, 5, 383–389. [Google Scholar]
- World Health Organization. WHO Guidelines on Good Agricultural and Collection Practices [GACP] for Medicinal Plants; WHO: Geneva, Switzerland, 2003. [Google Scholar]
- De Oliveira, E.C.; Fernandes, C.P.; Sanchez, E.F.; Rocha, L.; Fuly, A.L. Inhibitory effect of plant Manilkara subsericea against biological activities of Lachesis muta snake venom. BioMed Res. Int. 2014, 1–7. [Google Scholar]
- Harborne, J. Phytochemical Methods, London; Chapman and Hall: London, UK, 1973. [Google Scholar]
- Finney, D.J. Probit Analysis, 3rd ed.; Cambridge University Press: Cambridge, MA, USA, 1971. [Google Scholar]
- Borges, M.; Soares, A.M.; Rodrigues, V.; Oliveira, F.; Fransheschi, A.; Rucavado, A.; Giglio, J.; Homsi-Brandeburgo, M. Neutralization of proteases from Bothrops snake venoms by the aqueous extract from Casearia sylvestris (Flacourtiaceae). Toxicon 2001, 39, 1863–1869. [Google Scholar] [CrossRef]
- Amlabu, E.; Ebinbin, A.; Amlabu, W. Detoxification of Echis ocellatus venom-induced toxicity by Annona senegalensis Pers. J. Complement. Integr. Med. 2014, 11, 93–97. [Google Scholar]
- Pharmacopoeia, B.B., II. Medicines Act 1980. 1196 pp. Her Majesty’s Stationery Office; Atlantic House: London, UK, 1980. [Google Scholar]
- Laemmli, U.K. Cleavage of structural proteins during the assembly of the head of bacteriophage T4. Nature 1970, 227, 680–685. [Google Scholar] [CrossRef]
- Adams, R.P. Identification of Essential Oils by Ion Trap Mass Spectroscopy; Academic Press: Cambridge, MA, USA, 2012. [Google Scholar]
- Okot, D.F.; Namukobe, J.; Vudriko, P.; Anywar, G.; Allan, N.S.; Hedenreich, M.; Adebola, O.O.; Byamukama, R. Anti-venom potentials of Toona ciliata against cobra venom and chemical constituents of its essential and non-volatile oils. Mendeley Data 2021, 1, 1–5. [Google Scholar] [CrossRef]

| Group | Concentration (µg/g) | Mean Survival Time (h) | Percentage Death |
|---|---|---|---|
| 1 | 5 | 0.55 | 100 |
| 2 | 2.5 | 1.0 | 100 |
| 3 | 1.25 | 2.0 | 100 |
| 4 | 1.0 | 2.5 | 100 |
| 5 | 0.625 | 3.0 | 100 |
| 6 | 0.5 | 4.5 | 100 |
| 7 | 0.25 | 7.40 | 100 |
| 8 | 0.15 | 12 | 0 |
| 9 | 0.005 | 24 | 0 |
| Concentration | Log-Concentration | n | n | %n | *%n | Probits |
|---|---|---|---|---|---|---|
| 0.625 | −0.204119983 | 4 | 4 | 100 | 93.75 | 6.53 |
| 0.5 | −0.301029996 | 4 | 4 | 100 | 93.75 | 6.53 |
| 0.25 | −0.602059991 | 4 | 4 | 100 | 93.75 | 6.53 |
| 0.1 | −1 | 4 | 0 | 0 | 6.25 | 3.47 |
| 0.05 | −1.301029996 | 4 | 0 | 0 | 6.25 | 3.47 |
| Experiment | Dose | Group of Mice | Mean Survival Time (h) | |
|---|---|---|---|---|
| Venom | Control | 1.25 µg/g | I | 2.0 |
| T. ciliata | Aqueous Plant extract | 3.5 mg/g | II | No death * |
| T. ciliata | Aqueous Plant extract | 5.0 mg/g | III | No death * |
| Anticoagulant Activity (MCD-P) | |
|---|---|
| Venom Concentrations (μg/mL) | Mean Clotting time in minutes ± SD |
| Control (PBS) (no venom) | 3.92 ± 0.38 |
| 12.5 | 5.58 ± 0.44 |
| 25 | 9.25 ± 2.68 |
| 30 | 19.58 ± 3.8 |
| 40 | No clots |
| 50 | No clots |
| 100 | No clots |
| Extract Concentration in mg/mL | Mean Clotting Time (without Recalcification) (min) | Recalcification Time (min) | |
|---|---|---|---|
| Exp. 1 | Exp. 2 | ||
| 100 | 22.0 | No clots | No clots |
| 50 | 24.5 | No clots | No clots |
| 25 | 42.5 | No clots | No clots |
| 12.5 | No clots | 2.0 | 2.17 |
| 6.25 | No clots | 3.5 | 3.25 |
| 1 | No clots | 4.5 | 3.75 |
| Aqueous Extract Concentration (mg/mL) | Clotting Time (min) | Mean Clotting Time (min) | |
|---|---|---|---|
| Expt. 1 | Expt. 2 | ||
| 6.25 | 29.58 | 15.0 | 22.29 |
| 0.5 | 15.83 | 13.72 | 14.65 |
| 0.125 | 14.83 | 14.83 | 14.83 |
| 2MCD-P (25 μg/mL) | 11.0 | 11.0 | 11.0 |
| Antivenin (SAIMR) | 9.25 | 8.08 | 8.67 |
| Control (PBS) | 4.25 | 5.72 | 4.99 |
| Venom Concentration (μg/mL) | 2 | 10 | 12 | 14 | 16 | 18 | 20 | PBS Control 30 μL |
|---|---|---|---|---|---|---|---|---|
| Hemolytic Halos | 10 | 22 | 24 | 25 | 25 | 25 | 26 | 6 |
| Extract Concentrations (mg/mL) | 12.5 | 6.25 | 1 | 0.5 | 0.25 | 0.125 | PBS Control (30 μL) |
|---|---|---|---|---|---|---|---|
| Hemolytic Halos | 18 | 16 | 8 | 6 | 6 | 6 | 6 |
| Extract Concentrations (mg/mL) | 6.25 | 1 | 0.5 | 0.25 | Control (Venom,10 μg) |
|---|---|---|---|---|---|
| Hemolytic halos Mixture | 22 | 22 | 23 | 22 | 24 |
| % Inhibition | 8.33 | 8.33 | 4.17 | 8.33 | |
| Hemolytic halos extract only | 18 | 8 | 6 | 6 | |
| Control (PBS) only | 6 | 6 | 6 | 6 |
| No. | R. Time | % Area | Molecular Formula | Name | CAS NO | RI |
|---|---|---|---|---|---|---|
| 1 | 8.111 | 1.4 | C15H24 | Santalene | 512-61-8 | 1463 |
| 2 | 9.053 | 2.37 | C13H18O4 | 2-Butanone,4-(2,4,6-trimethoxyphenyl) | 53581-92-3 | 1550 |
| 3 | 9.477 | 0.61 | C15H25I | 6-β-Bicyclo [4.3.0]nonane, 5-β-iodomethyl-1-β-isopropenyl-4-α,5-α-dimethyl-, | 0-0-0 | 1589 |
| 4 | 9.573 | 0.97 | C17H2802 | Nerolidyl acetate (Sesquiterpenoid) | 2306-78-7 | 1599 |
| 5 | 9.909 | 0.8 | C15H24O | Isospathulenol (Sesquiterpenoid) | 88395-46-4 | 1630 |
| 6 | 9.976 | 1.86 | C15H26O2 | [5-(Hydroxymethyl)-2,5,8a-trimethyl-1,4,4a,6,7,8-hexahydronaphthalen-1-yl]methanol | 1796930-60-3 | 1636 |
| 7 | 10.078 | 0.72 | C15H24O | Salvial-4(14)-en-1-one (Sesquiterpenoid) | 73809-82-2 | 1645 |
| 8 | 10.195 | 1.07 | C17H2802 | 5-Azulenemethanol, 1,2,3,4,5,6,7,8-octahydro-α,α,3,8-tetramethyl-, acetate, [3S-(3-α,5-α,8-α)]- | 134-28-1 | 1656 |
| 9 | 10.274 | 2.67 | C15H24O | Humulene epoxide II | 19888-34-7 | 1663 |
| 10 | 10.37 | 1.28 | C20H26O | Benzene, 1,1′-(oxydi-2,1-ethanediyl)bis [3-ethyl- | 55044-9-2 | 1672 |
| 11 | 10.59 | 1.29 | C15H26O | τ-Muurolol | 19912-62-0 | 1693 |
| 12 | 10.773 | 20.0 | C15H26O | β-Himachalol | 1891-45-8 | 1710 |
| 13 | 10.826 | 1.28 | C15H26O | 3-Cyclohexen-1-ol, 1-(1,5-dimethyl-4-hexenyl)-4-methyl- | 15352-77-9 | 1715 |
| 14 | 10.862 | 2.06 | C15H24 | β-Panasinsene | 0-0-0 | 1718 |
| 15 | 11.397 | 0.58 | C15H26O | (-)-Globulol | 489-41-8 | 1769 |
| 16 | 13.403 | 0.71 | C14H28O2 | Dodecanoic acid, 10-methyl-, methyl ester | 5129-65-7 | 1969 |
| 17 | 13.712 | 1.40 | C16H22O4 | 1,4-Dibutyl benzene-1,4-dicarboxylate or Dibutyl Terephthalate (esther) | 1962-75-0 | 2000 |
| 18 | 13.768 | 1.1 | C19H22BNO2 | 9H-Carbazole, 9-methyl- | 1484-12-4 | 2006 |
| 19 | 14.24 | 2.25 | C15H26O | Bicyclo [6.3.0]undec-1(8)-en-3-ol, 2,2,5,5-tetramethyl- | 0-0-0 | 2056 |
| 20 | 16.3 | 0.9 | C15H26O2 | 3-Isopropyl-6,7-dimethyltricyclo [4.4.0.0(2,8)]decane-9,10-diol | 0-0-0 | 2286 |
| 21 | 18.079 | 44.34 | C21H24O5 | Rutamarin (Furanocoumarins) | 13164-5-1 | 2504 |
| 22 | 18.343 | 0.58 | C16H30O4Si3 | 2,6-Dihydroxybenzoic acid, 3TMS derivative | 3782-85-2 | 2538 |
| 23 | 18.696 | 1.16 | C18H17NO | Girinimbine (carbazole alkaloid) | 23095-44-5 | 2584 |
| 24 | 20.936 | 4.3 | C30H52O | β-Himachalol | 0-0-0 | 2894 |
| No. | RT | % Area | Molecular Formula | Compound Name | CAS NO | RI |
|---|---|---|---|---|---|---|
| 1 | 9.049 | 0.83 | C13H18O4 | 2-Butanone,4-(2,4,6-trimethoxyphenyl) | 53581-92-3 | 1550 |
| 2 | 9.181 | 0.76 | C15H24 | Santalene | 29550-55-8 | 1562 |
| 3 | 9.885 | 0.7 | C15H26O | 1H-Cycloprop [e]azulen-7-ol, | 6750-60-3 | 1627 |
| 4 | 9.97 | 0.76 | C15H26O | [5-(Hydroxymethyl)-2,5,8a-trimethyl-1,4,4a,6,7,8-hexahydronaphthalen-1-yl]methanol | 1796930-60-3 | 1635 |
| 5 | 10.3 | 1.03 | C15H26O | 1H-Benzocyclohepten-7-ol, 2,3,4,4a,5,6,7,8-octahydro-1,1,4a,7-tetramethyl-, cis- | 6892-80-4 | 1666 |
| 6 | 10.41 | 5.93 | C15H24 | β-Guaiene | 88-84-6 | 1676 |
| 7 | 10.583 | 0.87 | C15H26O | τ-Muurolol | 19912-62-0 | 1692 |
| 8 | 10.715 | 1.24 | C15H24O | 1-Aromadendren-10-ol | 63181-42-0 | 1704 |
| 9 | 10.758 | 7.61 | C15H26O | β-Himachalol | 1891-45-8 | 1709 |
| 10 | 10.887 | 3.13 | C15H26O | Allohimachalol | 19435-77-9 | 1721 |
| 11 | 10.979 | 0.78 | C15H26O | β-Acorenol | 28400-11-5 | 1730 |
| 12 | 11.11 | 1.31 | C15H24O | 4,9-Muuroladien-15-ol | 135118-51-3 | 1742 |
| 13 | 12.129 | 1.16 | C15H24O | cis-Z-α-Bisabolene epoxide | 0-0-0 | 1840 |
| 14 | 12.888 | 2.92 | C15H24O | 6-Isopropenyl-4,8a-dimethyl-1,2,3,5,6,7,8,8a-octahydro-naphthalen-2-ol | 0-0-0 | 1916 |
| 15 | 13.764 | 2.2 | C13H11N | 9H-Carbazole, 9-methyl- | 1484-12-4 | 2006 |
| 16 | 14.236 | 1.07 | C15H26O | Bicyclo [6.3.0]undec-1(8)-en-3-ol, 2,2,5,5-tetramethyl- | 0-0-0 | 2056 |
| 17 | 18.057 | 52.55 | C21H24O5 | Rutamarin | 13164-5-1 | 2501 |
| 18 | 18.152 | 0.6 | C18H21NO4 | Oxycodone | 76-42-6 | 2513 |
| 19 | 18.336 | 3.46 | C16H30O4Si3 | 2,6-Dihydroxybenzoic acid, 3TMS derivative | 3782-85-2 | 2537 |
| 20 | 18.692 | 3.94 | C18H17NO | Girinimbine | 23095-44-5 | 2583 |
| 21 | 20.929 | 0.94 | C20H32 | (E,E,E)-3,7,11,15-Tetramethylhexadeca-1,3,6,10,14-pentaene | 77898-97-6 | 2893 |
| No. | R. Time | % AREA | Molecular Formula | Name | CAS NO | RI |
|---|---|---|---|---|---|---|
| 1 | 8.582 | 0.52 | C12H24 | Cyclododecane | 294-62-2 | 1507 |
| 2 | 9.186 | 0.59 | C15H24 | γ-Elemene | 29873-99-2 | 1562 |
| 3 | 9.264 | 0.45 | C15H26O | (-)-Globulol | 489-41-8 | 1570 |
| 4 | 9.335 | 0.41 | C17H28O | (-)-Isolongifolol, acetate | 0-0-0 | 1576 |
| 5 | 9.379 | 0.39 | C11H24O | 1-Undecanol | 112-42-5 | 1581 |
| 6 | 9.513 | 0.77 | C15H26O | Cyclohexanemethanol, 4-ethenyl-α, α,4-trimethyl-3-(1-methylethenyl)-, [1R-(1α,3α,4-β.)]- | 639-99-6 | 1593 |
| 7 | 10.194 | 0.66 | C15H26O | α-epi-7-epi-5-Eudesmol | 446050-56-2 | 1656 |
| 8 | 10.285 | 1.86 | C20H30O2 | Boscartol F | 1486443-17-7 | 1664 |
| 9 | 10.42 | 10.06 | C15H24 | β-Guaiene | 88-84-6 | 1677 |
| 10 | 10.511 | 1.09 | C15H24O | 1H-Cycloprop [e]azulen-7-ol, decahydro-1,1,7-trimethyl-4-methylene-, [1ar-(1a-α,4a-α,7β,7aβ,7bα)]- | 6750-60-3 | 1685 |
| 11 | 10.612 | 1.97 | C15H26O | 1-Naphthalenol, 1,2,3,4,4a,7,8,8a-octahydro-1,6-dimethyl-4-(1-methylethyl)-, [1R-(1-α,4-β,4a-β,8a-β)]- | 19435-97-3 | 1695 |
| 12 | 10.721 | 3.61 | C15H26O | α-Cadinol | 481-34-5 | 1705 |
| 13 | 10.89 | 1.75 | C15H26O | (4aR,5R,9aR)-1,1,4a,8-Tetramethyl-2,3,4,4a,5,6,7,9a-octahydro-1H-benzo [7]annulen-5-ol | 19435-77-9 | 1721 |
| 14 | 10.97 | 2.01 | C15H26O | Cyclohexanemethanol, 4-ethenyl-.alpha.,.alpha.,4-trimethyl-3-(1-methylethenyl)-, [1R-(1-α,3-α,4-β)]- | 639-99-6 | 1729 |
| 15 | 11.118 | 9.53 | C15H24O | 4,9-Muuroladien-15-ol | 135118-51-3 | 1743 |
| 16 | 11.472 | 0.8 | C15H26O | 1H-Cycloprop [e]azulen-7-ol, decahydro-1,1,7-trimethyl-4-methylene-, [1ar-(1a-α,4a-α,7-β,7a-β,7b-α)]- | 6750-60-3 | 1776 |
| 17 | 11.754 | 0.41 | C15H24O | Ylangenol | 41610-69-9 | 1804 |
| 18 | 12.193 | 0.49 | C15H24O | ((8R,8aS)-8-Isopropyl-5-methyl-3,4,6,7,8,8a-hexahydronaphthalen-2-yl) methanol | 135118-52-4 | 1847 |
| 19 | 13.774 | 4.21 | C13H11N | 3-Methylcarbazole | 4630-20-0 | 2007 |
| 20 | 13.808 | 2.37 | C16H32O2 | n-Hexadecanoic acid | 57-10-3 | 2010 |
| 21 | 14.484 | 0.49 | C10H18O2 | Bicyclo(3.1.1)heptane-2,3-diol, 2,6,6-trimethyl- | 53404-49-2 | 2082 |
| 22 | 15.144 | 0.46 | C15H20O4 | Acetophenone, 4′-hydroxy-2′,6′-dimethoxy-3′-(3-methyl-2-butenyl)- | 18780-96-6 | 2155 |
| 23 | 15.48 | 6.18 | C13H28OSi | Citronellol, TMS derivative | 18419-9-5 | 2192 |
| 24 | 15.524 | 5.83 | C14H26O | 7-Tetradecenal, (Z)- | 65128-96-3 | 2197 |
| 25 | 15.766 | 0.42 | C14H20 | Bicylo [4.1.0]heptane, 7-bicyclo [4.1.0]hept-7-ylidene- | 0-0-0 | 2225 |
| 26 | 16.149 | 1.46 | C15H24O | 6-Isopropenyl-4,8a-dimethyl-1,2,3,5,6,7,8,8a-octahydro-naphthalen-2-ol | 0-0-0 | 2269 |
| 27 | 16.832 | 0.64 | C21H20O2 | 2-[1-(2-Acetylphenyl)ethyl]-6-methoxynaphthalene | 0-0-0 | 2350 |
| 28 | 17.253 | 0.45 | C25H41NO3Si | 2-Phenanthrenol, 1,2,3,4,4a,4b,5,6,8a,9,10,10a-dodecahydro-4a,7-dimethyl-8-[3-cyano-3-(trimethylsilyloxy)propyl]-, acetate | 0-0-0 | 2401 |
| 29 | 17.329 | 0.44 | C17H13NO2 | 2-naphthalenol, 1-(2-pyridinyl)-, acetate (ester) | 0-0-0 | 2410 |
| 30 | 18.033 | 15.15 | C21H24O5 | Rutamarin | 13164-5-1 | 2498 |
| 31 | 18.35 | 0.87 | C16H30O4Si3 | 2,6-Dihydroxybenzoic acid, 3TMS derivative | 3782-85-2 | 2539 |
| 32 | 18.71 | 6.68 | C18H17NO | Girinimbine | 23095-44-5 | 2585 |
| 33 | 19.135 | 3.98 | C15H14O3 | Isolapachol (1,4-Naphthalenedione, 2-hydroxy-3-(3-methyl-1-butenyl)-) | 4042-39-1 | 2642 |
| 34 | 19.461 | 0.5 | C14H14N2 | 3-(N-Methylamino)-9-methylcarbazole | 5416-98-8 | 2685 |
| 35 | 19.967 | 6.24 | C18H21N3 | Oprea1 | 54932-49-9 | 2755 |
| 36 | 20.086 | 1.16 | C19H19NO2 | Koenimbin (Carbazoles) | 21087-98-9 | 2772 |
| 37 | 22.008 | 0.64 | C26H52O2 | Hexadecanoic acid, dodecyl ester | 42232-29-1 | 3050 |
| 38 | 22.59 | 0.46 | C26H52O2 | Hexadecanoic acid, decyl ester | 42232-27-9 | 3127 |
| No. | R. Time | % Area | Molecular Formula | Name | CAS NO | RI |
|---|---|---|---|---|---|---|
| 1 | 7.222 | 1.34 | C15H24 | Cyclohexene, 4-ethenyl-4-methyl-3-(1-methylethenyl)-1-(1-methylethyl)-, (3R-trans)- | 20307-84-0 | 1378 |
| 2 | 7.351 | 0.37 | C15H24 | α-Cubebene | 17699-14-8 | 1391 |
| 4 | 7.655 | 2.04 | C15H24 | Cyclosativene (1,2,4-Metheno-1H-indene, octahydro-1,7a-dimethyl-5-(1-methylethyl)-, [1S-(1-α,2-α,3a-β,4-α,5-α,7a-β) | 22469-52-9 | 1420 |
| 6 | 7.749 | 5.05 | C15H24 | Longicyclene 1,2,4-Methenoazulene, decahydro-1,5,5,8a-tetramethyl-, [1S-(1-α,2-α,3a-β,4-α,8a-β,9R*)]- | 1137-12-8 | 1429 |
| 7 | 7.803 | 1.77 | C15H24 | (3R,4aS,5R)-4a,5-Dimethyl-3-(prop-1-en-2-yl)-1,2,3,4,4a,5,6,7-octahydronaphthalene | 24741-64-8 | 1434 |
| 8 | 7.97 | 0.4 | C9H11NO2 | Benzoic acid, 2-(methylamino)-, methyl ester | 85-91-6 | 1449 |
| 9 | 8.178 | 8.55 | C15H24 | Tricyclo [2.2.1.0(2,6)]heptane, 1,7-dimethyl-7-(4-methyl-3-pentenyl)-, (-)- | 512-61-8 | 1469 |
| 10 | 8.229 | 1.37 | C15H24 | Bicyclo [5.2.0]nonane, 2-methylene-4,8,8-trimethyl-4-vinyl- | 242794-76-9 | 1474 |
| 11 | 8.269 | 1.82 | C15H24 | trans-α-Bergamotene | 13474-59-4 | 1478 |
| 12 | 8.309 | 1.23 | C15H24 | 1H-Cyclopenta [1,3]cyclopropa [1,2]benzene, octahydro-7-methyl-3-methylene-4-(1-methylethyl)-, [3aS-(3a-α,3b-β,4-β,7 | 13744-15-5 | 1481 |
| 13 | 8.4 | 2.87 | C15H24 | Bicyclo [7.2.0]undec-4-ene, 4,11,11-trimethyl-8-methylene- | 13877-93-5 | 1490 |
| 15 | 8.599 | 2.21 | C15H24 | 3,11-Acoradiene (Spiro [4.5]dec-7-ene, 1,8-dimethyl-4-(1-methylethenyl)-, [1S-(1-α,4-β,5-α)]-) | 24048-44-0 | 1508 |
| 16 | 8.646 | 0.88 | C15H24 | (1S,4S,4aS)-1-Isopropyl-4,7-dimethyl-1,2,3,4,4a,5-hexahydronaphthalene | 267665-20-3 | 1513 |
| 8.766 | 4.68 | C15H24 | Copaene (Sesqueterpene) | 3856-25-5 | 1524 | |
| 17 | 8.886 | 8.1 | C15H24 | (1R,2S,6S,7S,8S)-8-Isopropyl-1-methyl-3-methylenetricyclo [4.4.0.02,7]decane-rel- | 18252-44-3 | 1535 |
| 18 | 8.953 | 0.64 | C15H24 | Ylangene | 14912-44-8 | 1541 |
| 19 | 9.01 | 3.24 | C15H24 | (1R,4aS,8aR)-1-Isopropyl-4,7-dimethyl-1,2,4a,5,6,8a-hexahydronaphthalene | 20085-19-2 | 1546 |
| 20 | 9.078 | 4.63 | C15H24 | Tricyclo [5.4.0.0(2,8)]undec-9-ene, 2,6,6,9-tetramethyl-, (1R,2S,7R,8R)- | 8/2/5989 | 1553 |
| 21 | 9.145 | 0.45 | C15H20 | α-Dehydro-ar-himachalene | 78204-62-3 | 1559 |
| 22 | 9.219 | 4.1 | C15H24 | Naphthalene, 1,2,3,5,6,8a-hexahydro-4,7-dimethyl-1-(1-methylethyl)-, (1S-cis)- | 483-76-1 | 1566 |
| 23 | 9.292 | 2.62 | C15H26O | 2H-3,9a-Methano-1-benzoxepin, octahydro-2,2,5a,9-tetramethyl-, [3R-(3-α,5a-α,9-α,9a-α)]- | 9/2/5956 | 1572 |
| 24 | 9.357 | 1.88 | C17H28O2 | (-)-Isolongifolol, acetate (Longifolane sesquiterpenoids) | 0-0-0 | 1578 |
| 25 | 9.42 | 1.32 | C15H22 | 4,4-Dimethyl-3-(3-methylbut-3-enylidene)-2-methylenebicyclo [4.1.0]heptane | 79718-83-5 | 1584 |
| 26 | 9.491 | 1.46 | C15H20 | 4-Isopropyl-6-methyl-1-methylene-1,2,3,4-tetrahydronaphthalene | 50277-34-4 | 1591 |
| 27 | 9.525 | 0.52 | C15H26O | Cyclohexanemethanol, 4-ethenyl-α,α,4-trimethyl-3-(1-methylethenyl)-, [1R-(1-α,3-α,4-β)]- | 639-99-6 | 1594 |
| 28 | 9.585 | 0.96 | C17H28O2 | Nerolidyl acetate | 2306-78-7 | 1599 |
| 29 | 9.724 | 1.1 | C15H24 | 1,5-Cyclodecadiene, 1,5-dimethyl-8-(1-methylethylidene)-, (E,E)- | 15423-57-1 | 1612 |
| 30 | 9.847 | 0.66 | C15H26O | trans-Sesquisabinene hydrate | 145512-84-1 | 1624 |
| 31 | 9.911 | 2.12 | C15H24O | Ylangenol | 41610-69-9 | 1630 |
| 32 | 9.991 | 2.12 | C15H26O2 | [5-(Hydroxymethyl)-2,5,8a-trimethyl-1,4,4a,6,7,8-hexahydronaphthalen-1-yl]methanol | 1796930-60-3 | 1637 |
| 33 | 10.089 | 0.96 | C15H24O | Salvial-4(14)-en-1-one | 73809-82-2 | 1646 |
| 34 | 10.21 | 1.54 | C15H24 | isoledene | 95910-36-4 | 1657 |
| 35 | 10.292 | 2.27 | C15H24 | α-Guaiene | 12/1/3691 | 1665 |
| 36 | 10.375 | 0.44 | C15H26O | (2E,4S,7E)-4-Isopropyl-1,7-dimethylcyclodeca-2,7-dienol | 198991-79-6 | 1673 |
| 37 | 10.443 | 4.4 | C15H24 | β-Guaiene | 88-84-6 | 1679 |
| 38 | 10.523 | 1.08 | C15H26O | epi-Cubenol | 19912-67-5 | 1687 |
| 39 | 10.619 | 1.99 | C15H26O | τ-Muurolol | 19912-62-0 | 1695 |
| 40 | 10.803 | 6.69 | C15H26O | (+)-2-Himachalen-7-ol | 1891-45-8 | 1713 |
| 41 | 10.879 | 2.21 | C15H24 | Neoisolongifolene | 26783-22-2 | 1720 |
| 42 | 10.912 | 1.9 | C14H22O2 | Menthol, 1′-(butyn-3-one-1-yl)-, (1S,2S,5R)- | 0-0-0 | 1723 |
| 43 | 10.997 | 2.58 | C15H26O | Cubenol not Cubebol | 21284-22-0 | 1731 |
| 44 | 11.128 | 1.2 | C15H24O | 4,9-Muuroladien-15-Ol | 135118-51-3 | 1744 |
| 45 | 12.135 | 0.37 | C14H24O2 | E,Z-5,7-Dodecadien-1-ol acetate | 0-0-0 | 1841 |
| 46 | 12.292 | 0.37 | C15H28 | 1-Pentadecyne | 765-13-9 | 1856 |
| 47 | 14.242 | 0.7 | C15H26O | Bicyclo [6.3.0]undec-1(8)-en-3-ol, 2,2,5,5-tetramethyl- | 0-0-0 | 2056 |
| 48 | 16.286 | 0.38 | C15H14O4 | Xanthoxyletin OR 5-Metoxy seselin | 84-99-1 | 2285 |
| 49 | 17.994 | 0.41 | C21H24O5 | Rutamarin | 13164-5-1 | 2493 |
| Class | Non-Volatile Isolated Oils | Volatile/Essential Oil |
|---|---|---|
| 2.2% | - |
| 6.67% | 60.0% |
| 48.89% | 25.0% |
| 10.0% | 2.5% |
| 3.33% | 2.5% |
| 7.78% | - |
| - | 2.5% |
| 2.2% | 5.0% |
| 2.5% | |
| 1.1% | - |
| 4.4% | - |
| 1.1% | - |
| 12.33% | - |
Disclaimer/Publisher’s Note: The statements, opinions and data contained in all publications are solely those of the individual author(s) and contributor(s) and not of MDPI and/or the editor(s). MDPI and/or the editor(s) disclaim responsibility for any injury to people or property resulting from any ideas, methods, instructions or products referred to in the content. |
© 2023 by the authors. Licensee MDPI, Basel, Switzerland. This article is an open access article distributed under the terms and conditions of the Creative Commons Attribution (CC BY) license (https://creativecommons.org/licenses/by/4.0/).
Share and Cite
Okot, D.F.; Namukobe, J.; Vudriko, P.; Anywar, G.; Heydenreich, M.; Omowumi, O.A.; Byamukama, R. In Vitro Anti-Venom Potentials of Aqueous Extract and Oils of Toona ciliata M. Roem against Cobra Venom and Chemical Constituents of Oils. Molecules 2023, 28, 3089. https://doi.org/10.3390/molecules28073089
Okot DF, Namukobe J, Vudriko P, Anywar G, Heydenreich M, Omowumi OA, Byamukama R. In Vitro Anti-Venom Potentials of Aqueous Extract and Oils of Toona ciliata M. Roem against Cobra Venom and Chemical Constituents of Oils. Molecules. 2023; 28(7):3089. https://doi.org/10.3390/molecules28073089
Chicago/Turabian StyleOkot, David Fred, Jane Namukobe, Patrick Vudriko, Godwin Anywar, Matthias Heydenreich, Oyedeji Adebola Omowumi, and Robert Byamukama. 2023. "In Vitro Anti-Venom Potentials of Aqueous Extract and Oils of Toona ciliata M. Roem against Cobra Venom and Chemical Constituents of Oils" Molecules 28, no. 7: 3089. https://doi.org/10.3390/molecules28073089
APA StyleOkot, D. F., Namukobe, J., Vudriko, P., Anywar, G., Heydenreich, M., Omowumi, O. A., & Byamukama, R. (2023). In Vitro Anti-Venom Potentials of Aqueous Extract and Oils of Toona ciliata M. Roem against Cobra Venom and Chemical Constituents of Oils. Molecules, 28(7), 3089. https://doi.org/10.3390/molecules28073089

